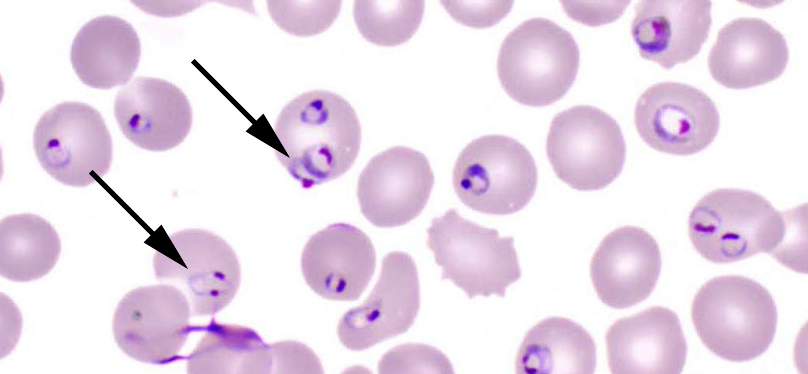
Plasmodium-falciparum2.jpg

Те из нас, кто любит путешествовать в жаркие страны, наслышаны об опасности заражения малярией. В переводе с итальянского дурной воздух. Неплохо было бы иметь представление о возбудителе этой инфекции, способах заражения, а также лечебных и профилактических мерах.
Большой вклад в изучение этого вопроса внесли такие ученые как Шарль Луи Альфонс Лаверан, Василий Яковлевич Данилевский, Илья Ильич Мечников, Дмитрий Леонидович Романовский. Карлос Хуан Финлей был одним их первых, кто предположил, что основными переносчиками инфекции являются комары. А английский ученый Дональд Росс обнаружил и экспериментально доказал наличие паразитического простейшего малярийного плазмодия в слюне и кишечнике женской особи комара рода Anopheles.
Итак, малярийный плазмодий возбудитель малярийной инфекции. По классификации простейших (одноклеточных) паразитов относится к типу Apicomplexa, классу Sporozoa (Споровики), отряду Haemosporida, семейству Plasmodiidae, роду Plasmodium.
В человеческом организме способны паразитировать 4 вида паразита:
- Plasmodium vivax возбудитель трёхдневной малярии;
- Plasmodium malariae возбудитель четырёхдневной малярии;
- Plasmodium falciparum возбудитель тропической малярии;
- Plasmodium ovale возбудитель ovale малярии, схожий с видом P. vivax.
Все разновидности в целом схожи по форме, строению и жизненным циклам, за исключением деталей. Но имеют свои особенности цикла развития; в основном по продолжительности его периодов.
Интересной особенностью паразитов типа Apicomplexa является способность чередования в жизненном цикле полового (гамогония) и бесполого (агамогония) способов размножения. При этом происходит смена хозяина. В человеческом организме, являющимся для малярийного плазмодия промежуточным хозяином, возможно только бесполое размножение. А фаза полового размножения прерогатива основного хозяина и переносчика малярии, то есть комара.
Общие характеристики
Организмы, которые составляют род Plasmodium они считаются эукариотами, что означает, что их клетки имеют три основных компонента каждой клетки: клеточную мембрану, цитоплазму и ядро.
Отличительной особенностью эукариотических организмов является то, что генетический материал (ДНК и РНК) ограничен мембраной в органелле, известной как ядро клетки..
Точно так же, помимо того, что являются эукариотами, члены этого рода одноклеточные, что означает, что они являются простыми существами, которые соответствуют одной клетке.
Точно так же они являются внутриклеточными паразитами. Паразитические формы организмов рода Plasmodium они должны проникать в клетки (гепатоциты в печени и эритроциты), чтобы размножаться и иметь возможность развиваться должным образом.
Большинство представителей жанра Plasmodium они патогены. Это означает, что они способны вызывать заболевания. Они могут вызывать заболевания у позвоночных, таких как рептилии, грызуны и птицы. В частности, у человека возбудителями малярии являются.
Для того, чтобы адекватно выполнить свой жизненный цикл, Plasmodium они требуют вектора. Это не что иное, как агент, функция которого заключается в транспортировке и передаче патогена от зараженного живого существа другому, которого нет..
В этом смысле вектор Plasmodium это самка рода комаров малярийный комар. Из более чем 400 видов этого комара только 30 являются переносчиками Plasmodium.
Врачи отмечают, что малярийный плазмодий представляет собой серьезную угрозу для здоровья человека, особенно в тропических и субтропических регионах. При попадании в организм, паразит проникает в эритроциты, где начинает активно размножаться, что приводит к разрушению клеток крови. Это вызывает анемию, лихорадку и другие симптомы, которые могут варьироваться от легкой формы до тяжелых осложнений. Специалисты подчеркивают важность ранней диагностики и своевременного лечения, так как запущенные случаи могут привести к летальному исходу. Профилактика, включая использование москитных сеток и репеллентов, играет ключевую роль в борьбе с распространением малярии. Врачи также акцентируют внимание на необходимости вакцинации и разработке новых методов лечения для снижения заболеваемости и смертности от этого опасного заболевания.
https://youtube.com/watch?v=jv9uTpM29Dc
Жизненный цикл Plasmodium Falciparum
Паразиты только на первый взгляд кажутся пластичными организмами. На самом деле их жизнь подчинена очень строгим правилам, отклонение от которых чревато гибелью для особи.
Жизненный цикл малярийного плазмодия это его путь развития от зародыша до половозрелой особи, способной размножаться.
Отличительной особенностью является тот факт, что цикл развития малярийного плазмодия функционально поделен на 2 части. Одна из них проходит в теле комара, другая в человеке.
Для того, чтобы плазмодий смог реализовать всю свою наследственную программу, он должен пройти следующие стадии развития.
- Заражение человека начинается с момента его укуса зараженным комаром. Пока самка комара пьет кровь, плазмодий в форме активно плавающего спорозоита вместе со слюной попадает в кровяное русло.
- В крови он проникает в эритроцит, увеличиваясь при этом в размерах. Такая трансформация порождает новое состояние плазмодия, которое называется шизонтом. Эта стадия развития необходима для того, чтобы осуществить бесполое размножение. Активное деление шизонтов в эритроцитах позволяет из одной большой клетки создать множество мелких, которые называются мерозоитами. При этом эритроцит полностью разрушается, а паразиты и токсины попадают в плазму крови.
На этом у человека заканчивается латентная стадия заболевания и начинается проявление первых симптомов.
Следующий этап жизненного цикла возбудителя малярии можно назвать полным захватом вражеской территории, если под таковой подразумевать все эритроциты человека. Мерозоиты, переносимые током крови, проникают в еще не разрушенные эритроциты. Так начинается следующий цикл развития плазмодия, который по-прежнему проявляется в бесполом размножении. 2 этап разрушения эритроцитов и новый выход мерозоитов в плазму крови порождает очередной приступ лихорадки со всеми характерными признаками.
На стадии повторного выхода из эритроцитов часть мерозоитов приобретает признаки половых, то есть мужских и женских клеток. Для того чтобы произошла следующая стадия развития в форме полового размножения, плазмодиям нужно попасть в тело комара.
Если им повезет, и комар выпьет кровь с такими клетками, то в его организме малярийный плазмодий окончательно созревает и превращается в гаметы. Именно в теле комара эти гаметы оплодотворяются, формируя яйцеклетку. Для дальнейшего развития яйцеклетка должна проникнуть в стенку кишечника комара. Там происходит ее превращение сначала в ооцисту, а затем в споробласты и, в конечном итоге, в спорозоиты. Именно они завершают жизненный цикл, поскольку на этой стадии малярийный плазмодий возвращается в то состояние, при котором через слюнные железы спорозоиты опять должны попасть в организм человека.
Стадии развития плазмодия объединили в единое целое 2 таких разных вида человека и комара. Остается открытым вопрос: кто для возбудителя малярии является главным звеном?
Что такое малярийный плазмодий
Этот простейший микроорганизм становится причиной развития опасного для жизни человека заболевания. Малярийный плазмодий это возбудитель малярии (malaria, протозойное заболевание, класс споровики), по данным ВОЗ во всем мире каждый год гибнет до 2 миллионов людей от данной болезни. Существуют разные виды паразитов, которые провоцируют разные формы патологии. Принята следующая классификация представителей этого класса:
- malariae заболевание имеет продолжительность 4 дня;
- plasmodium vivax (плазмодиум вивакс) трехдневный тип малярии;
- falciparum (фальципарум) тропический вид плазмодия малярийного;
- plasmodium ovale еще одна форма трехдневного заболевания;
- plasmodium knowlesi цикл репликации споровика 24 часа, поэтому любая инфекция (даже слабая) быстро перерастает в тяжелое заболевание.
Малярийный плазмодий вызывает множество обсуждений среди специалистов и простых людей. Многие отмечают, что это один из самых опасных паразитов, способных вызывать тяжелые заболевания. Врачи подчеркивают важность профилактики, особенно в регионах с высоким риском заражения. Люди делятся личными историями о том, как болезнь изменила их жизнь, заставив задуматься о здоровье и безопасности. Некоторые вспоминают о симптомах, таких как высокая температура и озноб, которые могут проявляться внезапно. Обсуждаются и методы лечения: от традиционных лекарств до новых подходов, разрабатываемых учеными. Важно также отметить, что общественное сознание постепенно меняется, и все больше людей осознают необходимость вакцинации и использования средств защиты от комаров.
https://youtube.com/watch?v=Yduq8NE7458
Основной хозяин малярийного плазмодия
Механизм того, как передается малярия, заключается в нескольких этапах созревания споровика. Для формирования спорогония нужно попасть в организм основного хозяина малярийного плазмодия комара анофелеса. На данном этапе гаметоциты уже находятся на стадии, когда они готовы к разделению на макрогаметоциты и микрогаметоциты. При укусе комара, носителя малярии, происходит переселение гаметоцитов к основному хозяину.
Внутри тела насекомого одна половина клеток становится мужскими, вторая женскими. Каждая из них имеет один хромосомный набор, при процессе слияния гамет разного пола формируются диплоидные клетки с полноценным набором хромосом. Так появляются, имеющие удлиненную форму, зиготы плазмодия малярийного. Они обладают высокой подвижность, сразу же проникают в стенки желудка комара, образуют спороцисты это клетки-инкубаторы, которые покрыты оболочкой.
Это последний цикл развития бактерии, внутри спороцистов продолжается клеточный митоз плазмодия малярийного, каждый такой инкубатор производит сотни спорозоитов. Затем оболочка инкубационного резервуара лопается, паразиты оказываются внутри тела насекомого и мигрируют к слюнным железам. Далее во время укуса зародыши плазмодия малярийного снова попадают в тело человека и заражают его.
Роль основного и промежуточного хозяина в циклах
Для описания паразитической формы жизни очень важны 3 понятия: основной, промежуточный и резервуарный хозяин.
Основным хозяином для паразита является тот вид, в котором происходит половое размножение. Здесь женская и мужская особи спариваются, в результате чего появляется особь с другим генотипом. Окончательным хозяином является и тот организм, в котором находится паразит с гермафродитным размножением. Ведь оплодотворение все равно происходит, хотя результатом этого процесса является появление клона, а не генетически новой особи.
Промежуточным хозяином является организм, в котором происходит бесполое размножение. Он нужен для того, чтобы увеличилось количество личинок.
Резервуарный хозяин это тот организм, который всего лишь кормит и содержит паразита.
Комар это основной хозяин малярийного плазмодия, а человек промежуточный. Резервуарный хозяин у этого паразита отсутствует.
Однако нельзя основного хозяина рассматривать как главное звено в жизненном цикле. Скорее это понятие следует трактовать в качестве среды, где завершается цикл развития.
Зачем же малярийному плазмодию тело человека, если основное его размножение происходит в теле комара? В чем вообще смысл промежуточных хозяев?
Объясняется это экологическими законами формирования устойчивого состояния популяции. Обычно паразит не стремится убить своего хозяина, потому что тогда он теряет не только источник пищи, но и комфортную среду существования. Существуют исключения из этого правила, но они крайне редки и представляют собой очень узкую специализацию паразита.
Человек нужен малярийному плазмодию для того, чтобы увеличить количество особей в период неполовой стадии развития. В теле комара плазмодий не смог бы достичь такой численности. Иметь одного хозяина в мире паразитов это увеличение риска вымирания. Однако и слишком большая взаимозависимость окончательного и промежуточного хозяев тоже увеличивают степень риска. Самый лучший вариант эволюция давно уже придумала это переход от паразитизма к симбиозу. Однако у малярийного плазмодия такой путь развития пока еще не наблюдается.
Строение Plasmodium Falciparum
Единственный путь, которым малярийный плазмодий проникает в организм человека, это укус комара. И из более трех тысяч существующих в природе видов этих двукрылых насекомых данный паразит переносится только малярийным комаром рода анофелес (Anopheles superpictus). Причем, этот комар обязательно должен быть самкой, так как именно ей нужна кровь как источник белков для выведения яиц.
В момент укуса комар впрыскивает в кожу человека слюну (чтобы кровь не свертывалась), и вместе со слюной в кожу попадают спорозоиты малярийного плазмодия. Спорозоит репродуктивная форма только одной стадии жизненного цикла этого протиста. Строение малярийного плазмодия на стадии спорозоитов имеет вид продолговатых и слегка изогнутых клеток размером не более 15 мкм.
Основной хозяин малярийного плазмодия комар анофелес, поскольку в его организме плазмодий занимается спорогонией (половым размножением). А человек промежуточный хозяин малярийного плазмодия, так как организм Homo sapiens он использует для агамогенеза, то есть бесполого размножения. Биологи выяснили, что у одноклеточных рода Plasmodium бесполое размножение имеет особую форму шизогонии, когда первоначальная клетка делится не на две дочерние, а сразу на множество. Таким образом размножение малярийного плазмодия адаптировано к способу его распространения от одного хозяина к другому.
Малярийные комары
Переносчиком малярии является один единственный род комаров. Этот род называется Anopheles. Этот род комаров насчитывает несколько сотен видов. Но это вовсе не означает, что каждый такой комар переносит болезнь в себе, некоторые из них являются абсолютно безвредными насекомыми. Ареал обитания комара этого рода очень велик, да практически по всему миру, кроме тех регионов, где круглый год бушуют морозы. В нашей стране их можно в встретить в Сибири и на Дальнем Востоке, но были случаи обнаружения в Московской и Ленинградской областях. Развитие личинок комаров происходит в воде, поэтому для среды их обитания характерна влажность и сырость. Особенно это можно заметить в жаркое время года.
Важно! Вопреки распространённому с детства мнению, что малярийные комары большие, на самом деле размеры их достигают всего нескольких миллиметров в длину. И отличаются от обычных комаров расположением туловища при посадке задний конец сильно задран вверх. У обычных посадка параллельна с поверхностью.
Внешне заразный комар от обычного ничем не отличается, поэтому определить у него бактерии можно только с помощью специализированного анализа на наличие малярии.
Классификация малярийного плазмодия
Малярийный плазмодий, согласно классификации простейших организмов классифицируется как:
среда обитания
Если среда обитания произносится в строгом смысле этого слова, то следует подтвердить, что среда обитания Plasmodium это кровь человека, так как именно в нем он выполняет большую часть своего жизненного цикла.
Именно в крови паразит имеет в своем распоряжении необходимые условия окружающей среды, чтобы иметь возможность спокойно развиваться и впоследствии заражать других.
Аналогично Plasmodium это организм, который полностью распределен по всей планете. Однако у каждого вида есть свой регион влияния. Здесь они упомянут самые известные и место, где они наиболее распространены.
Плазмодий вивакс Это особенно распространено в азиатских странах, таких как Индия, Шри-Ланка, Бангладеш, Непал и Пакистан.. Plasmodium falciparum преобладает в регионе Африки к югу от Сахары и Плазмодий овальный Это изобилует в Западной Африке, Индонезии, на Филиппинах и в Папуа-Новой Гвинее.
Важно знать об этом, потому что, если человек путешествует, он должен быть проинформирован о возможных заболеваниях, которые он может заразить. Особенно если они путешествуют в развивающиеся страны, где много малярии.
Традиционное лечение
В медицинской практике для лечения малярии используют этиотропную терапию, направленную на локализацию и борьбу с возбудителем заболевания. Для ее эффективности важна предварительная лабораторная диагностика и правильный подбор препаратов. В зависимости от вида малярийного плазмодия и стадии болезни пациенту могут быть назначены различные противомалярийные препараты, а также сочетание препаратов.
Прогуанил и Примахин уничтожают паразитов на стадии их развития в печени, а Хинин и Атоваквон действуют аналогично в эритроцитах. Хлорохин убивает половые клетки плазмодия. Бигумаль и Примахин используют для профилактики и предотвращения рецидивов.
В случае недостаточной эффективности других средств, применяются антибиотики: Тетрациклин и Доксициклин. В зависимости от наличия других патологий и осложнений на фоне малярии могут применяться также Фуросемид, Клемастин, Маннитола и др. При тропической форме малярии используют сочетание Пириметамина и Дапсона.
В комплексе с основной, этиотропной терапией, используют также детоксикационные меры (для быстрого вывода из организма токсичных продуктов жизнедеятельности паразитов) и патогенетическое лечение (для восстановления иммунных реакций и функций отдельных органов, нормализации обменных процессов в организме).
Кровь на малярийный плазмодий
Кровь на малярийный плазмодий берут из пальца на руке обычным способом, а затем делают на стерильном предметном стекле мазок крови, который изучают под микроскопом.
Поскольку виды малярийных плазмодиев несколько различаются друг от друга по своему строению, то каждый вид имеет четкие диагностические признаки.
К таким признакам специалисты относят и строение малярийного плазмодия, и характер изменения пораженных эритроцитов. Как правило, такие красные кровяные тельца увеличены, некоторые меняют свою форму и цвет и т.д.
Интересные факты
По данным исследователей, предок современного паразита малярийного плазмодия существовал как независимый простейший и был способен к фотосинтезу. Распространение инфекции предположительно началось из Центральной и Западной Африки примерно 50000 лет назад. А первые письменные свидетельства о болотной лихорадке (так называли малярию в древности) датируются 2700 годом до н.э.
От малярийной лихорадки умерли Чингисхан, Данте, лорд Байрон, Христофор Колумб и многие известные личности.
Первое известное лекарство против малярии растение Кингао, содержащее артемизинин. Сейчас артемизинин выделяют из полыни однолетней и используют при лечении трехдневной формы малярии.
Другим древним средством от малярии считается порошок из коры хинного дерева, который индейцы использовали для лечения лихорадки любой этиологии. Они и поделились с европейцами чудесным секретом исцеления.
В медицинских исследовательских центрах Техаса и Вашингтона ведутся совместные испытания препарата от малярии нового поколения. Лекарство способно останавливать развитие болезни на любой стадии жизненного цикла малярийного плазмодия внутри организма человека. Достаточно однократного приёма нового медикамента.
Современные виды малярийного плазмодия способны к мутации и вырабатывают со временем устойчивость к тем или иным противомалярийным препаратам, в частности, к Хлорохину.
Открытие в конце XX века спящей стадии развития малярийного плазмодия в клетках печени, так называемого, гипнозоита, позволило ученым объяснить факты рецидивов заболевания спустя несколько месяцев и лет в организме человека.
Ученые Америки и Австралии установили причину слабой активности иммунной системы человека по отношению к малярии. При заражении клеток паразит оставляет один из видов своего белка, которых в запасе его генетики около 50 видов! Прежде чем иммунная система человека распознает и отреагирует на чужеродный белок, паразит уже вырабатывает новый вид. Эта эволюционная защита ДНК простейшего позволяет ему безопасно паразитировать в теле человека на протяжении длительного времени.
А ученые Англии выяснили, что морские обитатели трепанги синтезируют белок, который блокирует размножение малярийного плазмодия. Исследователи попытались привить полезный ген трепангов комарам переносчикам болезни, но пока не добились 100 процентного результата в своих экспериментах.
В научных институтах Америки, Англии и Нидерландов активно ведутся разработка и тестирование новых вакцин от малярии. Добровольцам за деньги предлагается участие в эксперименте, в ходе которого они подвергнутся заражению этой инфекцией. Процесс лечения занимает три дня. Всё время эксперимента испытуемые находятся под наблюдением врачей.
https://youtube.com/watch?v=i5SR4xbN_84%3Ffeature%3Doembed
Лечение малярии
Основная задача терапии этого заболевания заключается в предотвращении возникновения/повторения приступов, полном уничтожении возбудителя. Болезнь малярия или болотная лихорадка чаще встречается в эндемичных районах, поэтому путешественникам следует принимать профилактические меры заранее. Лечение малярии проводят при помощи медикаментозной терапии, используют, как правило, Примахин, Хлорохин, Атабрин (хинакрин гидрохлорид), Акрихин.
Лекарства от малярии
Медикаментозная терапия при данном заболевании считается эффективным методом. Существуют проверенные лекарства от малярии, которые применяются на протяжении длительного времени. Примером таких медикамента выступает Хинин, который был заменен Хлорохином на некоторое время, но затем снова начал активно использоваться. Причиной этому послужило возникновение, а затем распространение в Азии и Африке Plasmodium falciparum, который имел резистентность к Хлорохину.
В зависимости от региона, где произошло заражение, могут быть использованы те или иные препараты против плазмодия малярийного. Большинство из них подходят как для лечения, так и профилактики. Экстракт полыни однолетней, содержащие артемизинин и аналоги синтетического происхождения, обладают высокой эффективностью, но и высокую стоимость. Большую опасность болезнь представляет для жителей, которые проживают в эндемических областях, где доступа к препаратам нет. В развитых странах проблем с приобретением медикаментов не наблюдается.
Диагностика малярии
Для подтверждения диагноза используют изучение под микроскопом образца. Лабораторная диагностика малярии заключается в заборе крови из пальца обычным методом. Мазок наносится на стерильное предметно стекло, которое изучается специалистом под увеличением. Диагностика малярии помогает выявить разные виды плазмодиев, каждый из них имеет определенные диагностические признаки. Определить зараженные эритроциты в анализе можно по изменение размера, формы или цвета.
Профилактика малярийных плазмодиев
До сегодняшнего дня никому не удалось создать вакцину против малярии, поэтому так важна профилактика малярийных плазмодиев.
В эндемичных для малярии районах земного шара профилактика малярийных плазмодиев, в первую очередь, она направлена на уничтожение комаров Anopheles с помощью инсектицидов.
Для индивидуальной защиты от укусов малярийных комаров применяют различные репелленты (жидкие, в виде кремов и аэрозолей), надевают закрытую одежду и противокомариные сетки, которые также опрыскивают репеллентами.
Есть специальные фармацевтические препараты для профилактики малярийных плазмодиев. Отправляясь в места, где распространена малярия и существует вероятность ее подцепить, эти средства необходимо принимать заранее.
Например, противомалярийное средство Делагил (Хлорохин, Резохин) в таблетках принимают по 0,5 г дважды в течение неделю, а потом по 0,5 г один раз в неделю. Действие препарата базируется на способности его активного вещества производного 4-аминохинолина тормозит синтез нуклеиновых кислот и тем самым уничтожать клетки малярийного плазмодия.
Данное средство противопоказано при нарушениях работы почек и печени, тяжелой сердечной недостаточности, снижении кроветворной функции костного мозга. Его также нельзя принимать беременным и детям дошкольного возраста. Медики отмечают, что, покинув малярийно опасную местность, препарат нужно продолжать принимать еще как минимум месяц.
Как знать, что бы еще завоевал Александр Македонский и что бы сделал для Англии Оливер Кромвель, если бы их не укусил малярийный комар, и малярийный плазмодий не вызвал бы смертельную болезнь.
Вопрос-ответ
Где в организме человека паразитирует малярийный плазмодий?
Возбудители – малярийные плазмодии паразитируют поочередно в двух хозяевах: в самке комара рода Anopheles и в человеке. Во время укуса комар вводит в кровяное русло человека спорозоиты, которые уже через несколько минут попадают в печень. В гепатоцитах происходит цикл шизогонии, длящийся не менее 7 суток.
Как человек заражается малярийным плазмодием?
Проникновение малярийных плазмодиев в организм человека может происходить на разных стадиях разными путями: При укусе комаром заражение происходит на спорозонтной стадии. Проникшие плазмодии через 15-45 минут оказываются в печени, где начинается их интенсивное размножение.
Как человек может заразиться малярийным плазмодий?
Малярия в основном передаются людям с укусами инфицированных самок комаров рода Anopheles. Передача малярии может также происходить при переливании крови или использовании инфицированных инъекционных игл.
Где в теле человека размножается малярийный плазмодий?
В организм человека спорозоиты из слюнных желёз насекомого попадают при кровососании, далее спорозоиты проникают в клетки печени, где происходит бесполое размножение (экзоэритроцитарная шизогония) — молодые шизонты созревают и когда число ядер в них достигает определенного в зависимости от вида числа (от 8 до 32 в
Советы
СОВЕТ №1
Изучите симптомы малярии, такие как высокая температура, озноб, потливость и головная боль. Это поможет вам своевременно обратиться за медицинской помощью при подозрении на заболевание.
СОВЕТ №2
Используйте средства защиты от комаров, такие как репелленты и москитные сетки, особенно если планируете поездки в районы, где малярия распространена.
СОВЕТ №3
Пройдите курс профилактического лечения, если собираетесь в эндемичные зоны. Консультируйтесь с врачом о подходящих медикаментах и их применении.
СОВЕТ №4
Регулярно проверяйте свое здоровье после возвращения из тропических стран, даже если вы не испытываете симптомов. Раннее выявление малярии может спасти жизнь.